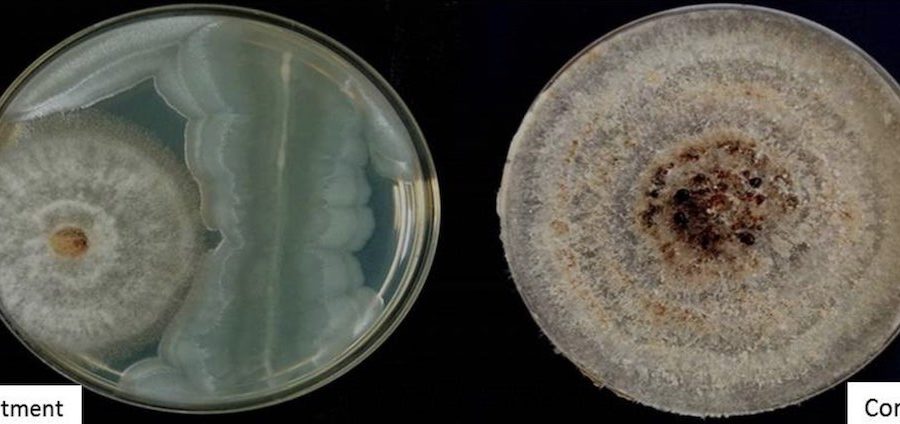

Statistical analyses of plant metabolites allow solid testing of plant defense theories for the first time

High-throughput analyses of small substances in Nicotiana attenuata reveal that plants re-organize their metabolism to produce highly-specific defense metabolites after insect attack
Isabel25/06/2020